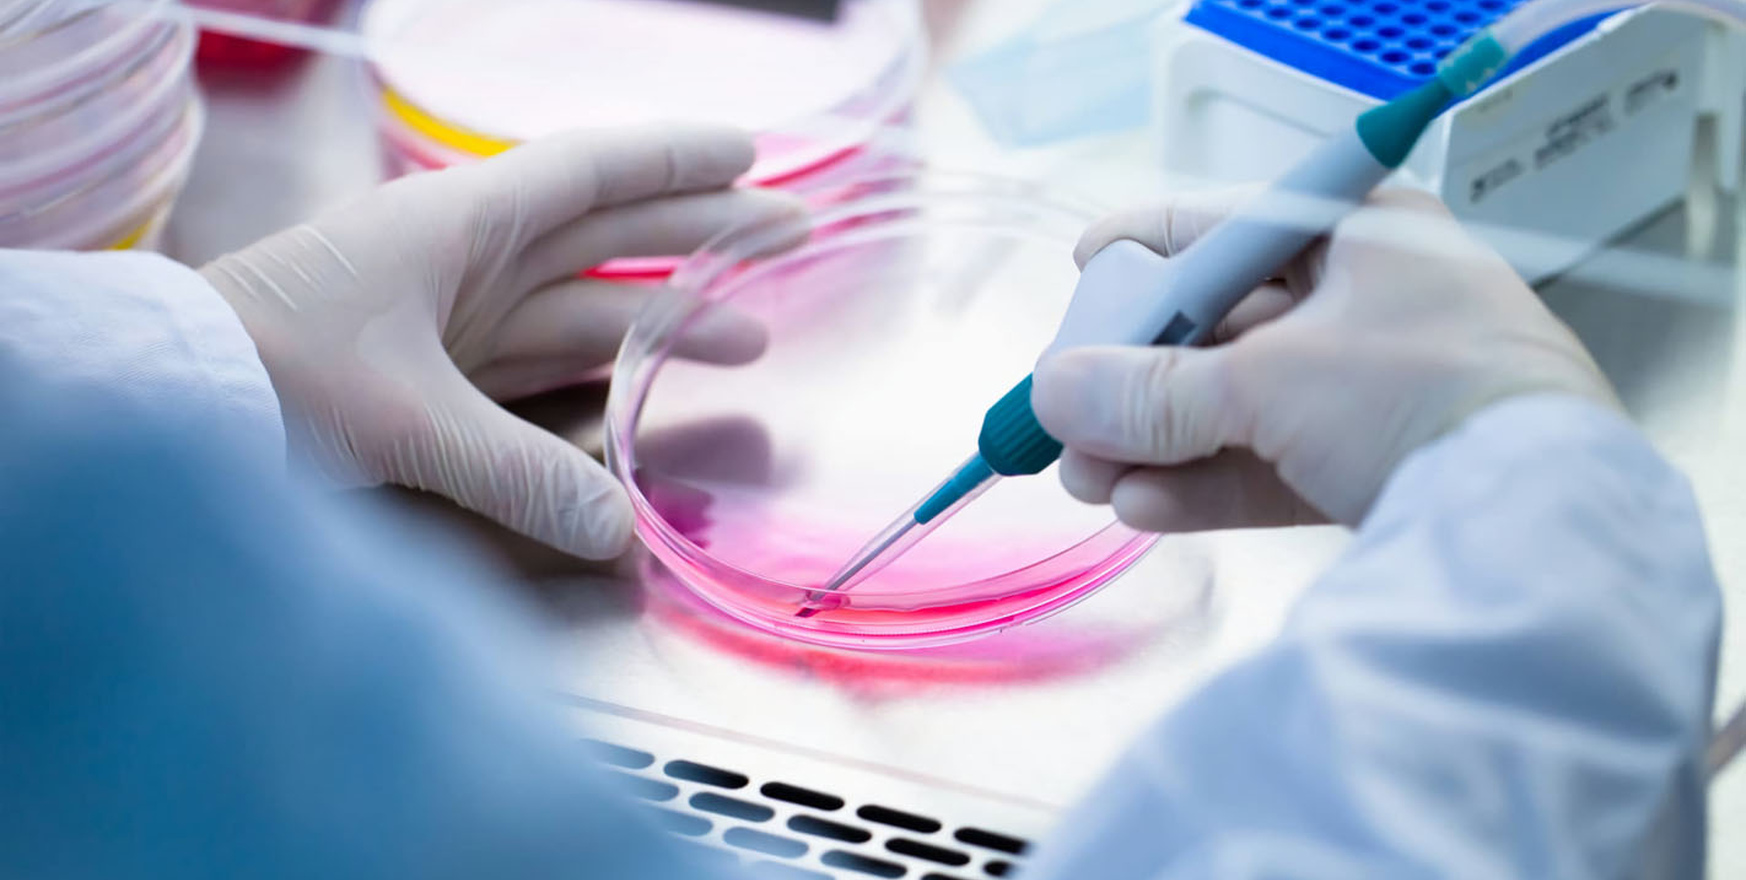

Эндокардиальная имплантация стволовых клеток — это инновационная медицинская процедура, направленная на восстановление сердечной ткани у пациентов с тяжёлыми заболеваниями сердца. В ходе этой процедуры стволовые клетки вводятся непосредственно в эндокард (внутренний слой стенки сердца) для стимулирования регенерации повреждённого миокарда, улучшения кровоснабжения и повышения функциональности сердца.
Стволовые клетки, обладая способностью к дифференцировке и самовосстановлению, вводятся в повреждённые участки сердца. Они способствуют:
- Регенерации ткани. Замене повреждённой или рубцовой ткани новыми клетками.
- Ангиогенезу. Образованию новых кровеносных сосудов, что улучшает кровоснабжение сердца.
- Снижению воспаления. Уменьшению воспалительного процесса, характерного для хронических заболеваний сердца.
- Улучшению функции сердца. Повышению сократительной способности миокарда.
Когда применяется имплантация стволовых клеток?
Основные показания для процедуры:
- Хроническая сердечная недостаточность. Развитие слабости сердечной мышцы вследствие ишемии или инфаркта миокарда.
- Ишемическая болезнь сердца (ИБС). Улучшение кровоснабжения поражённых участков миокарда.
- Кардиомиопатия. Восстановление функции сердца при структурных изменениях сердечной мышцы.
- Рубцовые изменения миокарда. Лечение последствий инфаркта миокарда для улучшения сократительной способности сердца.
Как проводится эндокардиальная имплантация стволовых клеток?
- Подготовка к процедуре. Пациент проходит полное обследование, включая ЭКГ, эхокардиографию, ангиографию и анализы крови. Стволовые клетки получают из костного мозга или жировой ткани самого пациента, после чего их выращивают и готовят к введению.
- Проведение процедуры. Имплантация проводится через катетеризацию сердца под местной анестезией. С помощью специального катетера стволовые клетки вводятся непосредственно в поражённые участки сердечной мышцы (эндокардиально). Введение осуществляется под контролем УЗИ или ангиографического оборудования.
- Процедура занимает около 1–2 часов. После её завершения пациент находится под наблюдением специалистов.
Преимущества метода
- Малоинвазивность. Нет необходимости в открытой операции на сердце.
- Естественное восстановление. Использование собственных клеток пациента минимизирует риск отторжения.
- Подходит для пациентов с противопоказаниями к хирургии. Возможность лечения, когда другие методы неэффективны или невозможны.
- Улучшение качества жизни. Уменьшение симптомов, таких как одышка, усталость и боль в груди.
Долгосрочные результаты
- Улучшение функции сердца. Повышение фракции выброса и сократительной способности миокарда.
- Снижение риска осложнений. Уменьшение вероятности повторных инфарктов и прогрессирования сердечной недостаточности.
- Повышение выживаемости. Метод помогает продлить жизнь пациентам с тяжёлыми формами сердечных заболеваний.
Эндокардиальная имплантация стволовых клеток проводится в специализированных медицинских центрах Беларуси с использованием передовых технологий. Высококвалифицированные специалисты обеспечивают точное проведение процедуры и безопасное введение клеток. Этот инновационный метод позволяет улучшить качество жизни пациентов с серьёзными сердечно-сосудистыми заболеваниями.